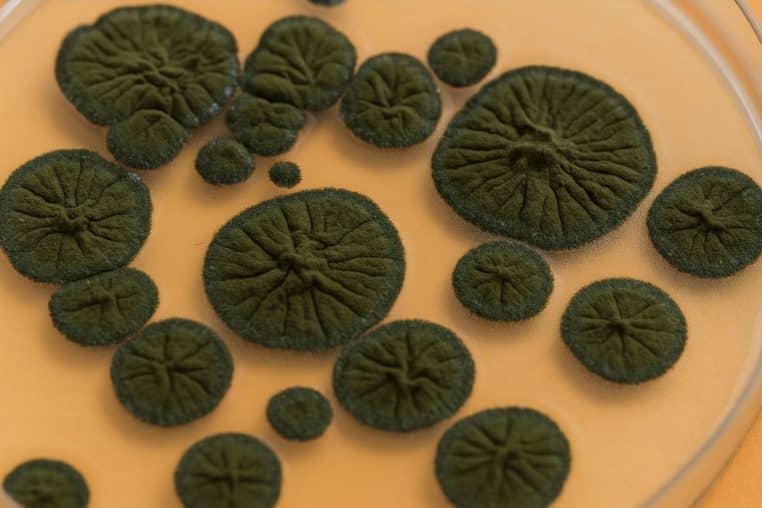
Champignons de Tchernobyl

Des scientifiques analysent les champignons noirs de Tchernobyl et découvrent qu’ils détiennent le secret permettant les voyages spatiaux
Un champignon observé à Tchernobyl intrigue les scientifiques : sa résistance exceptionnelle pourrait transformer la façon dont nous voyageons dans l’espace.

Les champignons noirs de Tchernobyl suscitent un intérêt scientifique croissant depuis une découverte impressionnante. Ils ont démontré une capacité étonnante à se développer dans des zones exposées à des niveaux extrêmes de radiation.
Une caractéristique qui pourrait, un jour, aider la NASA et d’autres agences spatiales à protéger les astronautes lors de voyages de longue durée. Cette aptitude exceptionnelle fait de Cladosporium sphaerospermum l’une des espèces les plus étudiées pour son potentiel dans l’exploration au-delà de la Terre.
Un champignon né dans l’extrême : pourquoi Tchernobyl fascine les chercheurs
Les premières observations remontent à la fin des années 1990. Des chercheurs ont alors identifié une communauté de champignons sombres accrochée aux parois du réacteur accidenté.

Le groupe dominé par Cladosporium sphaerospermum ne se contentait pas de résister à la radiation. Il présentait, par ailleurs, une croissance inhabituelle dans des environnements dans lesquels l’ionisation détruit généralement les molécules essentielles à la vie.
La forte concentration de mélanine dans les parois cellulaires a été la première piste pour expliquer ce comportement hors du commun.
La mélanine, clé d’un mécanisme biologique encore mystérieux
Les analyses ont montré que ce pigment subit des modifications structurelles lorsqu’il est exposé à la radiation ionisante. Cela a ainsi conduit les chercheurs à envisager un rôle de convertisseur énergétique.
Selon certains spécialistes, ce processus pourrait s’apparenter à une forme de « radiosynthèse », même si cette hypothèse n’a pas encore été confirmée de manière définitive.
Des études supplémentaires ont révélé qu’en présence de sources radioactives comme le césium, ce champignon pouvait accroître sa croissance d’environ 10 %. Ce phénomène ne concerne toutefois pas toutes les espèces mélanisées, et des validations expérimentales supplémentaires restent nécessaires.
Un potentiel immense pour les futures missions sur la Lune et Mars
L’intérêt international pour cette espèce a conduit à l’envoi d’échantillons de Cladosporium sphaerospermum à la Station spatiale internationale. Pendant plusieurs mois, ils ont été exposés au bombardement constant des radiations cosmiques.

Les résultats ont révélé une croissance supérieure à celle de cultures témoins restées sur Terre. En plus, des chercheurs ont observé une réduction partielle du flux radioactif traversant la fine couche de mycélium.
Ces observations ouvrent la voie au développement de matériaux légers, auto-réparables et fabriqués à partir de biomasse fongique. Ces matériaux seraient capables d’agir comme boucliers protecteurs lors des missions lunaires ou martiennes.
La possibilité de produire ces matériaux directement sur place réduirait considérablement la masse transportée depuis la Terre. Elle faciliterait également la construction d’habitats sûrs pour les astronautes.
Tchernobyl, un laboratoire naturel pour comprendre l’adaptation du vivant

La zone d’exclusion de Tchernobyl demeure un laboratoire naturel unique. La vie continue de prouver, grâce à ces exemples incroyables, sa capacité d’adaptation dans des environnements extrêmes.
Même si le mécanisme précis qui permet à ces champignons de prospérer sous forte radiation reste encore à élucider, leur comportement ouvre de nouvelles pistes pour améliorer la protection spatiale. Il pourrait de cette manière permettre de développer des technologies essentielles à l’exploration du cosmos.